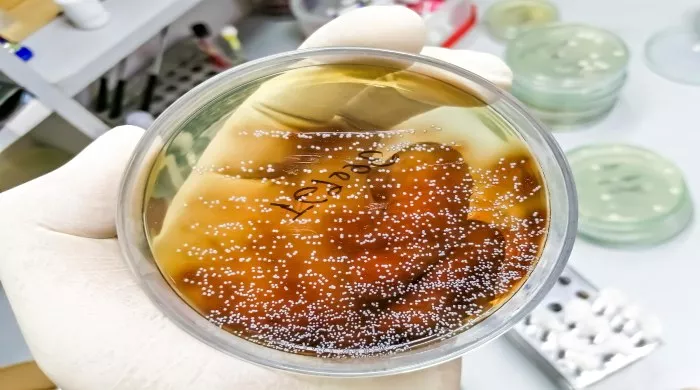
kandida

VEZA GLJIVICE I POREMEĆAJA
Jedna studija američkih naučnika otkrila je da postoji povezanost infekcije koju izaziva gljivica kandida sa mentalnim problemima kod ljudi.
Oni objašnjavaju da kandida kasnije može imati produžene posledice po naš mozak, ali za sada ove teorije su u ranoj fazi, pa se sve ovo ne može zasigurno tvrditi.
– Rano je reći da jedna infekcija kandidom može da uzrokuje mentalni problem. Međutim, većina gljivičnih infekcija mora da bude lečena u ranom stadijumu, a lekari bi trebalo posebnu pažnju da obrate kod pacijenata sa već postojećim mentalnim problemima – rekla je dr Emili Severans, vođa istraživanja iz medicinske škole Džon Hopkins univerziteta.
Gljivica kandida uobičajeno se nalazi u ljudskim crevima, ali ona počinje da se razmnožava i buja u toploj, vlažnoj sredini, izazivajući svrab, crvenilo, a karakteristično je i da se lako prenosi na drugoga.
Ove infekcije se mogu sprečiti smanjenjem unosa šećera i redovnim održavanjem higijene. Gotovo 75 odsto odraslih žena u SAD imalo je barem jednu vaginalnu gljivičnu infekciju tokom života, a gljivična infekcija usta i grla veoma je česta kod beba.
Faktori koji mogu da povećaju rizik od dobijanja gljivične infekcije:
– stres
– manjak sna
– bolest
– loše navike u ishrani, posebno previše slatkiša
– trudnoća
– menstruacija
– uzimanje steroida, kontraceptivnih pilula i antibiotika
– hormonske promene Lečenje se sprovodi antimikoticima u obliku krema, tableta i vaginaleta
Tim naučnika testirao je 808 osoba, neke od njih su imale šizofreniju ili bipolarni poremećaj, a druge nisu imale istoriju mentalnih bolesti. Zatim su uzeli u obzir i druge faktore poput godišta, rase, socio-ekonomskog statusa, lekova koje piju…
Pronašli su da 26 odsto muškaraca sa šizofrenijom ima antitela na kandidu, što znači da su nekada u životu bili inficirani ovom gljivicom, u poređenju sa samo 14 odsto muškaraca u kontrolnoj grupi koji nisu imali mentalnih problema.
Ista veza nije pronađena kod žena, ali su žene koje su već imale psihičkih problema imale znatno lošiju memoriju ukoliko su ranije bolovale i od gljivičnih infekcija.
– Iako ne možemo da preciziramo kakva je to veza između infekcije kandidom i psihološkog procesa u mozgu, naši podaci pokazuju da su neki faktori povezani sa gljivičnom infekcijom, što bi nadalje trebalo detaljnije ispitati- kaže dr Severans.
Postoji, međutim, mnogo ograničenja ove studije – na primer istraživači nisu uspeli da eliminišu sve spoljne faktore koji dovode, odnosno izazivaju gljivičnu infekciju: dijetu i trenutno stanje imunog sistema. Naučnici, takođe, nisu mogli da otkriju u kom periodu života, i u kom delu tela se javila gljivična infekcija, kao i koliko često se javljala kod ispitanika koji su učestvovali u studiji.
Ali, ovo je samo prvi korak, tim naučnika će sada da radi na otkrivanju uzročne veze mentalnih bolesti i kandide, a već postoje i nagoveštaji drugih istraživanja kako ta veza u stvari funkcioniše.
– Kandida je prirodna komponenta ljudskog mikrobioma, pa razmnožavanje gljivice i širenje infekcije u digestivnom traktu može da naruši ono što se u medicini zove osovina mozak -creva. Ova neravnoteža utiče na abnormalno funkcionisanje imunog sistema koji remeti procese u mozgu, posebno vezane za memoriju – objašnjava dr Severans.
Izvor: Srbija danas